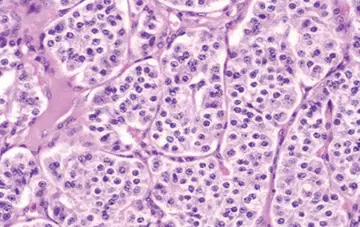

شماره ۱۱۲۵
داروسازی - صفحه 7
شماره ۱۱۷۷
عوارض جانبی شایع قابل انتظار درMvasi شامل خونروی از بینی(اپیستاکسی)، سردرد، فشار خون بالا، التهاب حفره بینی(رینیت)، دفع بالای پروتئین در ادرار(پروتئینوری)، تغییرحسچشایی(Taste alteration)، پوست خشک، خونروی رکتال، تولید اشک بالا(Lacrimation disorder)، التهاب پوستی (درماتیت پوستهریزیدهنده) و درد پشت است.
شماره ۱۱۲۴
لورم ایپسوم متن ساختگی با تولید سادگی نامفهوم از صنعت چاپ و با استفاده از طراحان گرافیک است.
شماره ۱۱۲۳
شماره ۱۱۲۳
شماره ۱۱۲۲
شماره ۱۱۲۰
شماره ۱۱۱۹
شماره ۱۱۱۹